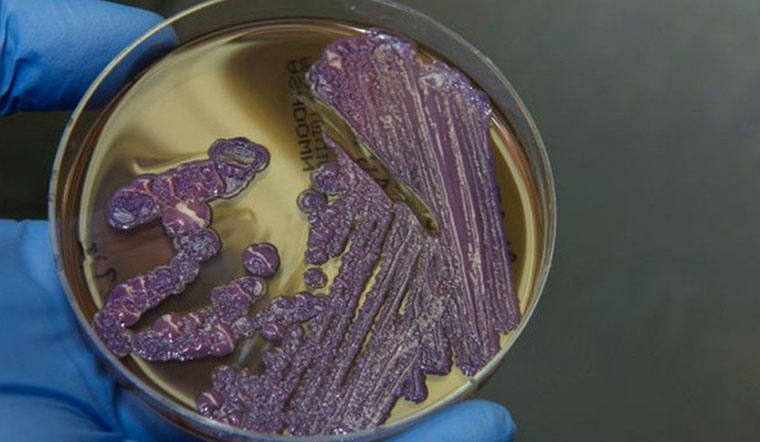
Tắm biển có sợ nhiễm bệnh Whitmore

Trái với những thông tin gần đây, các bác sĩ chuyên khoa khẳng định Whitmore không phải là vi khuẩn ăn thịt người và hoàn toàn có thể chữa trị được.
Trong thời gian gần đây, các trang báo liên tục đưa thông tin nhiều người được phát hiện nhiễm vi khuẩn Whitmore, một loại vi khuẩn được mệnh danh vi khuẩn ăn thịt người có khả năng ăn mòn da thịt của nạn nhân khiến cho rất nhiều người hoang mang và lo lắng.
Tuy nhiên theo PGS.TS Bùi Vũ Huy cho biết, vi khuẩn Whitmore không được gọi là vi khuẩn ăn thịt người và người mắc bệnh hoàn toàn có thể chữa trị được. Cùng tìm hiểu thêm thông tin chi tiết ngay sau đây.
1Whitmore không phải "vi khuẩn ăn thịt người"
Theo nguồn tin từ trang Sức khỏe và đời sống, PGS.TS Bùi Vũ Huy - Giảng viên Cao cấp Bộ môn Truyền nhiễm, Đại Học Y Hà Nội - Cố vấn Khoa nhi, BV Bệnh Nhiệt Đới Trung ương, nơi đã từng tiếp nhận, điều trị cho nhiều bệnh nhân nhiễm Whitmore khẳng định: “Bệnh Whitmore không phải là bệnh “ăn thịt người” như dư luận đồn thổi trong thời gian vừa qua”.
Vi khuẩn Whitmore là một loại vi khuẩn tồn tại trong bùn, đất, nước nhiễm bẩnvà chỉ lây qua người thông qua các vết xước, vết thương ngoài da. Những người có sức đề kháng kém hay mắc các bệnh mạnh tính rất dễ bị nhiễm vi khuẩn này.

Khi vi khuẩn Whitmore xâm nhập vào cơ thể sẽ có những triệu chứng dễ nhầm lẫn với các bệnh khác khiến người bệnh chủ quan và không đến các cơ sở y tế để xét nghiệm kịp thời.
Trường hợp bệnh nhân không phát hiện và điều trị kịp bằng thuốc kháng sinh sẽ gây ra hoại tử các cơ quan trên cơ thể như xương cánh mũi, xương hàm,...
Như vậy, trong trường hợp bệnh nặng thì vi khuẩn Whitmore mới gây ra hoại tử, thực chất Whitmore không có khả năng "ăn" các tế bào nên không thể gọi là vi khuẩn "ăn thịt người" như một số thông tin hiện nay. Điều này sẽ gây tâm lý hoang mang cho mọi người.
2Vì sao Whitmore lại gia tăng trong thời gian gần đây
Lý giải vì sao thời gian gần đây các ca bệnh nhiễm Whitmore lại tăng cao,TS Trịnh Thành Trung, Viện trưởng Viện Vi sinh vật và Công nghệ Sinh học, ĐH Quốc gia Hà Nội cho biết, tại Việt Nam, ca nhiễm bệnh đầu tiên được phát hiện tại TP.HCM vào năm 1925, sau đó ghi nhận ở Hà Nội và Huế lần lượt vào năm 1928 và 1936. Đây không phải là một căn bệnh mới mà đã có từ rất lâu.

Trong thời kỳ chiến tranh, các binh lính Mỹ cũng bị phơi nhiễm và nhiều cựu binh sau khi về nước mới phát bệnh. Từ đó Whitmore được mệnh danh là "Vietnamese time-bomb; tức quả bom hẹn giờ của Việt Nam".
Sau chiến tranh, đất nước đối diện với nhiều dịch bệnh cũng như điều kiện thiết bị y tế lúc bấy giờ cũng rất thiếu thốn. Hầu hết các thiết bị xét nghiệm đều cho ra kết quả sai cùng với các triệu chứng Whitmore gần giống với các bệnh khác nên bác sĩ chẩn đoán bệnh không chính xác.
Tuy nhiên thời gian gần đây, điều kiện về trang thiết bị y tế được nâng cao, xét nghiệm vi sinh tại các bệnh viện cũng được chú trọng, các bác sĩ được cảnh giác về bệnh Whitmore nên tỉ lệ bệnh nhân nhiễm bệnh được chẩn đoán đúng.
TS Trung nhấn mạnh: "Chính vì được chẩn đáon đúng nên số lượng ca bệnh tăng chứ không phải bệnh đột ngột quay trở lại và bùng phát thành dịch".
3Whitmore hoàn toàn chữa trị được
Theo PGS.TS Bùi Vũ Huy khẳng định “Chỉ cần bác sĩ xác định đúng bệnh nhiễm khuẩn Whitmore và điều trị theo phác đồ thì sẽ khỏi hoàn toàn. Bệnh không dễ dàng lây lan, không trực tiếp lây từ người qua người, người dân không nên lo lắng”.
Quan trọng, khi cơ thể xuất hiện những triệu chứng bệnh, người bệnh cần đến ngay các trung tâm y tế gầ nhất để được kiểm tra kịp thời. Bên cạnh đó, người dân cũng cần có những biện pháp phòng tránh bệnh hiệu quả.
Để chủ động phòng bệnh Melioidosis (Whitmore), Bộ Y tế khuyến cáo người dân cần thực hiện:
- Hạn chế tiếp xúc với đất hoặc nước bùn, đặc biệt là những nơi bị ô nhiễm nặng.
- Sử dụng giày, dép và găng tay đối với những người thường xuyên việc ngoài trời, tiếp xúc với đất và nước bẩn, đặc biệt đối với những người có nguy cơ cao.
- Khi có vết thương hở, vết loét hoặc vết bỏng cần tránh tiếp xúc với đất hoặc nước có khả năng bị ô nhiễm. Nếu bắt buộc phải tiếp xúc thì sử dụng băng chống thấm và cần được rửa sạch đảm bảo vệ sinh.
- Những người có bệnh mãn tính như tiểu đường, suy giảm miễm dịch cần được chăm sóc, bảo vệ các tổn thương để ngăn ngừa nhiễm khuẩn.
- Khi nghi ngờ nhiễm bệnh cần đến cơ sở y tế để được tư vấn, khám phát hiện, xét nghiệm xác định nhiễm vi khuẩn B. pseudomallei và điều trị kịp thời.
Khi cơ thể có dấu hiệu không khỏe nên đến bác sĩ để được thăm khám và tư vấn. Việc đến khám sớm là cần thiết trong tất cả các trường hợp mắc bệnh, chứ không riêng gì bệnh whitmore, từ đó bác sĩ sẽ có tư vấn, chỉ định phù hợp, tránh mất thời gian khiến bệnh trở nặng hơn.
Bạn sẽ quan tâm: